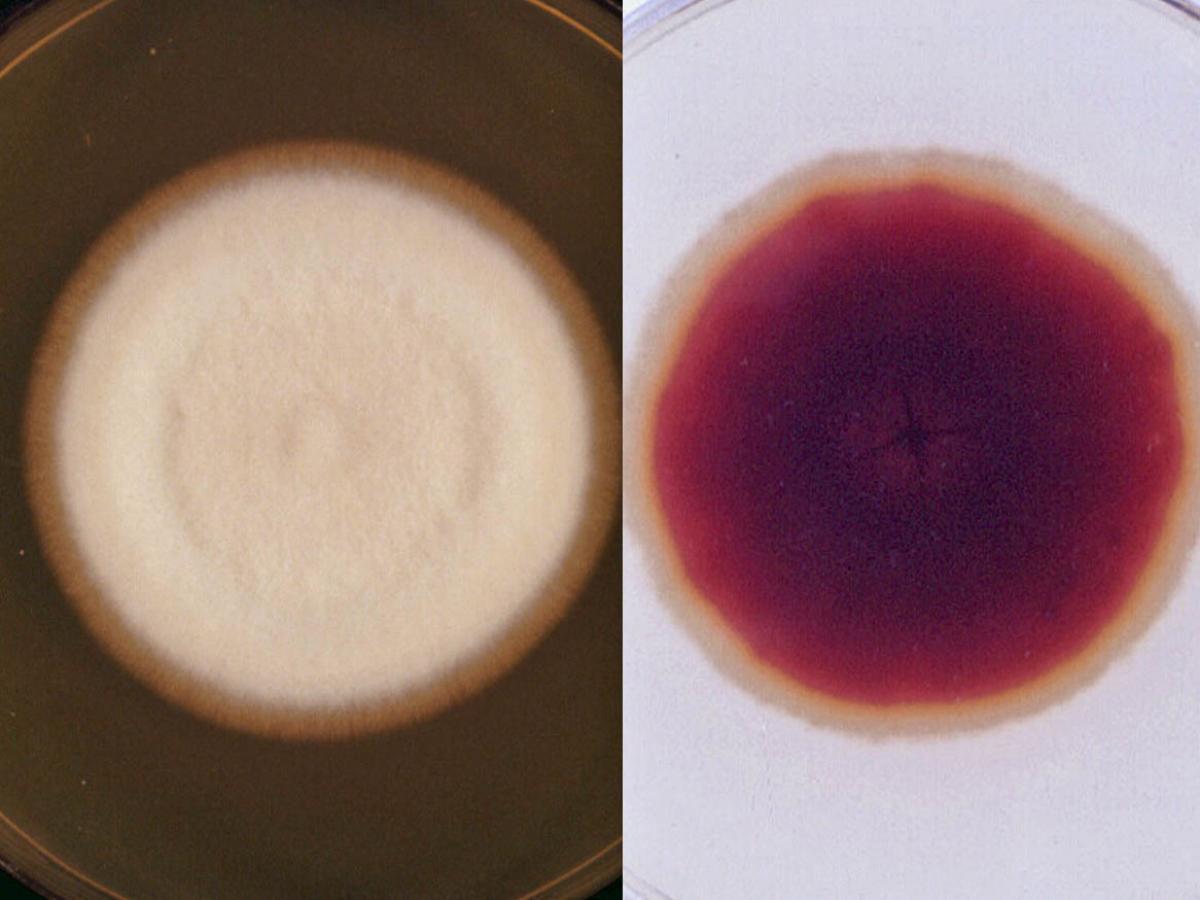
Culture

Status message
Correct! Excellent, you have really done well. Please find additional information below.
Unknown 49 = Trichophyton rubrum
Clinical presentation: Tinea of the nails caused by T. rubrum.

Direct microscopy: KOH mount of infected nail material showing typical dermatophyte hyphae breaking up into arthroconidia.

Culture: Colonies of T. rubrum are flat to slightly raised, white to cream, suede-like to downy, with a yellow-brown to wine-red reverse. Note: On primary isolation some cultures may lack reverse pigmentation and fail to produce microconidia. These will need to be subcultured onto media like Lactritmel agar or potato dextrose agar which stimulate pigmentation and sporulation. If sporulation still fails subculture the fungus onto Trichophyton Agar No.1. RG-2 organism.
Microscopy: Most cultures show scanty to moderate numbers of slender clavate to pyriform microconidia. Macroconidia are usually absent, however closterospore-like projections may be present in some mounts.

Comment: Trichophyton rubrum is an anthropophilic dermatophyte. The downy strain has become the most widely distributed dermatophyte of man. It frequently causes chronic infections of skin, nails and rarely scalp.
About Trichophyton Back to virtual assessment